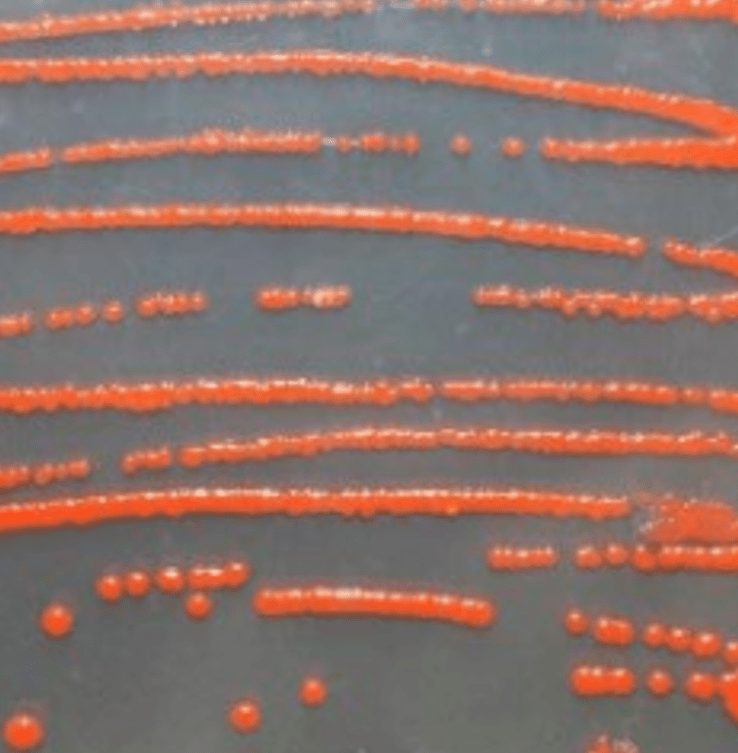
Von Bakterien produzierter Farbstoff in der Petrischale (c) karin Fleck - Vienna Textile Lab

Die Textilindustrie verwendet große Mengen an umweltbelastenden Farbstoffen. Eine mögliche Alternative sind Farbpigmente aus Bakterien. Die Pigmente entstehen in einem Schutzmechanismus und schützen die winzigen Lebewesen vor Licht. Im EU-Projekt Dye Another Way wird derzeit untersucht, wie sich daraus biologische Farbstoffe im industriellen Maßstab produzieren lassen.
Foto oben: (c) Victor Volkov VHRyXMrIHwg Unsplash
Erschienen am 22.11.2025 in die Presse Wissenschaft
Die Textilindustrie färbt seit 150 Jahren mit synthetischen Farbstoffen. Aus Erdöl gewonnen, sind sie meist nicht biologisch abbaubar und verschmutzen Gewässer und Böden. Das Problembewusstsein steigt und damit auch die Nachfrage nach ökologischen Färbeprozessen. Eine traditionelle Alternative sind pflanzliche Farbstoffe, die allerdings klimaabhängig sind und wertvolle Ackerflächen wegnehmen. Eine ideale Lösung könnten bestimmte Bakterien sein, die aufgrund ihrer Genetik Pigmente als Stoffwechselprodukt herstellen.
Bakterien sind in der Luft, im Boden oder im Wasser zu finden, werden aber auch in wissenschaftlichen Sammlungen geführt. Nicht alle produzieren Pigmente, aber die, die es tun, sind meist Extremophile. So bezeichnet man Mikroorganismen, die in extremer Hitze oder Kälte mit extremer Licht- und UV-Belastung bestehen können. Die Pigmente entstehen in einem Schutzmechanismus und schützen die kleinen Lebewesen vor Licht – vergleichbar mit Sonnencreme bei Menschen“, erklärt Professor Heidi Halbwirth, Leiterin der Forschungsgruppe Phytochemie und Biochemie der Naturstoffe an der TU Wien.
Derzeit forscht sie vor allem an farbstoffproduzierenden Bakterien, um diese für die Textil- und Lebensmittelindustrie nutzbar zu machen. Als Leiterin des EU-geförderten Projekts Dye Another Way bringt sie Partner aus Wissenschaft und Industrie aus mehreren Ländern zusammen. Das Projekt ist Teil des Marie Skłodowska-Curie-Programms, das neben der Forschung auch die Ausbildung junger Talente fördert: Doktorandinnen und Doktoranden aus unterschiedlichen Disziplinen arbeiten an eigenen Projekten und erhalten zusätzlich praxisnahe Trainings bei Partnerinstitutionen im gesamten Netzwerk.
Auf der Suche nach dem besten Farbstoffproduzenten
Die Pigmente der verschiedenen Bakterien unterscheiden sich in ihren Eigenschaften und Farben. Um den besten „Farbstoffproduzenten“ zu finden, analysieren die Forschungspartner ein möglichst breites Spektrum an Bakterienarten. Zunächst liegt der Fokus auf den Farben Rot, Blau und Schwarz. Langfristig soll ein komplettes Set an biologischen Farbstoffen für die industrielle Anwendung entwickelt werden.
Allen Typen gemeinsam ist, dass sie die Pigmente auf spezialisierten Stoffwechselwegen mit Hilfe von Enzymen (Proteinen) bilden. Aber was genau dabei passiert, ist von Typ zu Typ verschieden. Es sei grundlegend, diese „Produktionswege“ zu verstehen, um sie im Labor nachzeichnen und optimieren zu können. Beispielsweise um den geringen Pigment-Output der winzigen Lebewesen zu steigern – denn das sei eine große Hürde, so Halbwirth.
Außerdem charakterisieren die Forschenden die beteiligten Enzyme, um zu verstehen, welche davon Pigmenten bilden und unter welchen Bedingungen sie optimal arbeiten. Dinge wie pH-Wert oder Temperatur sind wichtig, um geeignete Produktionsbedingungen und Prozessparameter festzulegen. Ein Thema, an dem Halbwirth selbst forscht.
Wichtigste Eigenschaften: Brillanz, Wasch- und Lichtecht
Um den Output zu steigern, verfolgen die Forschenden zwei Strategien: Einerseits optimieren sie die Fermentation im Reaktor, wobei sie direkt mit den pigmentbildenden arbeiten und andererseits zeichnen sie den Herstellungsweg der mikrobiellen Farbstoffe in industriell genutzten mikrobiellen Produktionsplattformen nach.
Halbwirths Kollege Florian Rudroff vom Institut für Angewandte Synthetische Chemie an der TU Wien, forscht unter anderem an der Optimierung der Farbeindrücke. Farben wirken emotional und Konsumierende sind die satte Wirkung synthetischer Farben gewohnt. Mit der Wasch- und Lichtechtheit der Pigmente beschäftigen sich gleich mehrere Teams, da sie bei Textilien essenziell ist. Um Typen, die kaum über diese Eigenschaften verfügen, von vornherein auszuschließen, erfolgen diese Tests schon vor der aufwändigen Identifizierung des Pigments.
Last but not least versuchen die Forschenden das Verhalten der Farbstoffe im Lebenszyklus zu optimieren. Dabei spielt auch die eingesetzte Menge eine Rolle. Im besten Fall lassen sich die Pigmente im Kreislauf zu führen, sodass möglichst wenig davon ins Abwasser gelangt, so die Projektleiterin.
Link zur Website: http://www.dyeanotherway.eu
Der Markt für textile Farbstoffe in Zahlen
40,7 Mrd. USD betrug der Wert des globalen Farbstoff- und Pigmentmarktes im Jahr 2022.
Der Markt wächst jährlich um 4,9%. Bis 2029 erwartet man eine Umsatzsteigerung auf 56,9 Mrd. USD.
¼ der globalen Textilimporte fällt immer noch auf Europa. Trotz der asiatischen Dominanz.
Hildegard Suntinger
